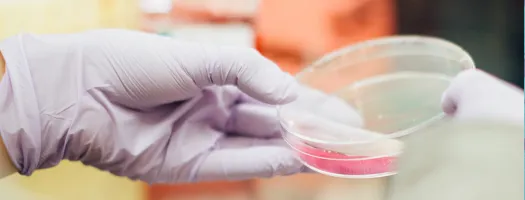
Project

Funded by the European Union
Within the framework of the European Union Chemical, Biological, Radiological and Nuclear Risk Mitigation Centres of Excellence (EU CBRN CoE) Initiative, the second project phase of Project 3 “Knowledge development and transfer of best practice on biosafety, biosecurity and biorisk management” has commenced. During this phase, National Experts of the 22 countries involved in the project will carry out the training addressed to the National Participants selected among national institutions, laboratories and hospitals. The topics featured during these local courses have been chosen by the National Experts in order to tailor the training contents on the primary national needs concerning biosafety and biosecurity.
After the first fruitful phase, when the National Experts of four regions (African Atlantic Façade; North Africa; South East Asia; and, South East Europe, Ukraine, the Caucasus and Moldova) attended a comprehensive training on biosafety, biosecurity and biorisk management, Project 3 has moved forward with a further step. Through this initial training, the National Experts are now empowered as trainers in their own countries and are expected to spread knowledge and best practices acquired according to the train-the-trainers project approach and national needs.
The local trainings will be carried out from January to March 2015, and the first countries to implement these trainings were Ukraine, Serbia and Cambodia. The status of phase two of Project 3 in the respective regions is outlined below.
African Atlantic Façade
The first national training in this region has taken place in Mauritania (January, 27-29 2015) in the capital Nouakchott. With the collaboration of the Project 3 Regional Coordinator, Expertise France, the Mauritanian National Experts of the Institut National de Recherché En Santé Publique (INRSP) carried out a training involving 27 participants from all over the country showing a high level of commitment. Several discussions were conducted concerning the topics identified as most important for the region, such as laboratory biorisk management, regulatory aspects of biosafety and biosecurity and laboratory accreditation.
South East Asia
Up to the end of January, Cambodia (Phnom Pehn, January, 22-23) Vietnam (Ha Noi, January, 27) and Lao (Vientiane, January, 29-30) carried out their training sessions. Between 16/18 National Participants were trained in each of the above mentioned countries by the National Experts. All the national experts involved showed and outstanding pro-activity and commitment, with a particular attention to Genetically Modified Organisms (GMOs) and teaching methodologies.
South East Europe, the Southern Caucasus, Moldova and Ukraine
Ukraine and Serbia kicked-off the National Participants training in this region, respectively on January, 19-30 in Kiev (12 participants) and January 22-23 in Belgrade (25 participants). Participants showed a strong commitment and proactive attitude throughout the courses , exchanging experiences and knowledge and highlighting the need for team work in order to improve standards of biosecurity and biosafety in microbiological laboratories, as part of an overall strategy for biological defense.
North Africa
Tunisia and Algeria will organize and carry out their training in the beginning of March 2015.
The EU CBRN CoE Initiative is funded by the European Commission and implemented in cooperation with the United Nations Interregional Crime and Justice Research Institute (UNICRI) and the European Commission Joint Research Center (JRC). The European External Action Service is also involved in the follow-up of the initiative. The initiative is developed with the technical support of relevant international and regional organisations, the EU Member States and other stakeholders, through coherent and effective cooperation at the national, regional and international level. The initiative involves 48 countries in 8 regions of the world
For more information:
CBRN Centres of Excellence website: http://www.cbrn-coe.eu/
European Commission, Instrument contributing to Stability and Peace website:
http://ec.europa.eu/dgs/fpi/what-we-do/instrument_contributing_to_stability_and_peace_en.htm